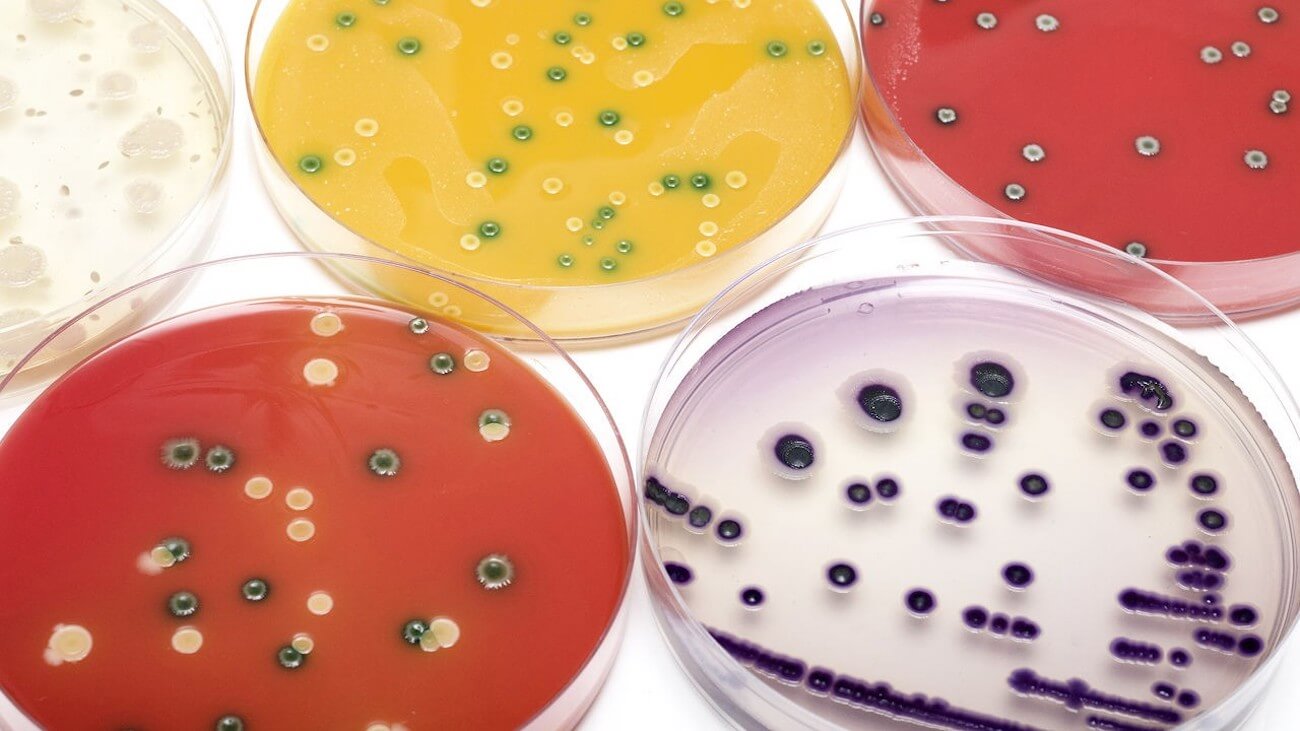

Ванкомицин Относится

👉🏻👉🏻👉🏻 ВСЯ ИНФОРМАЦИЯ ДОСТУПНА ЗДЕСЬ, ЖМИТЕ 👈🏻👈🏻👈🏻
Ванкомицин
Ванкомицин — описание вещества, фармакология, применение . . .
Ванкомицин - инструкция по применению и аналоги в таблетках
Ванкомицин: инструкция по применению, аналоги, состав . . .
Ванкомицин: инструкция по применению, показания, цена . . .
Ванкомицин: инструкция по применению . Цена, отзывы . . .
Что представляет собой ванкомицин, инструкция по . . .
Ванкомицин: инструкция по применению, аналоги препарата
Лекарственный мониторинг Ванкомицина
Ванкомицин: аналоги и инструкция по их применению
Бисептол Отзывы Принимавших
Бринтелликс 20 Мг Отзывы
Вазаламин Цена В Ростове На Дону
По фармакологическому указателю ванкомицин относится к группе «Противомикробные, противопаразитарные и противоглистные средства», подгруппе «Антибиотики» и ее подгруппе «Гликопептиды» . По АТХ : группа « A07 Противодиарейные препараты », подгруппа «A07A Кишечные противомикробные и противовоспалительные препараты», код A07AA09
Ванкомицина гидрохлорид — трициклический антибиотик группы гликопептидов, выделенный из Amycolatopsis orientalis (Nocardia orientalis) . Молекулярная масса 1485,71 . Хорошо растворим в воде, умеренно — в метаноле, слабо — в высших спиртах, ацетоне и эфире . Фармакологическое действие Фармакологическое действие - антибактериальное, бактерицидное .
Ванкомицин ® относится к резервным препаратам, которые должны применяться строго по назначению врача . Препарат хорошо зарекомендовал себя в лечении инфекций, вызванных штаммами бактерий, обладающих резистентностью к пенициллинам и цефалоспоринам . Также препарат эффективен при стафилококковых энтероколитах и антибиотикоассоциированной диарее .
Ванкомицин является антибиотиком, который относится к группе антибиотиков, называемых «гликопептидами» . Ванкомицин действует, уничтожая некоторые бактерии, вызывающие инфекции . ВАНКОМИЦИН можно использовать как раствор для инфузий или как раствор для перорального применения .
Антибиотик Ванкомицин относится к группе гликопептидов, предназначенных для терапии бактериальных инфекций тяжелого течения . Целесообразно назначение препарата при отсутствии лечебного результата при использовании пенициллинов и цефалоспоринов или при их непереносимости . Содержание статьи Состав и форма выпуска Показания Курс лечения
medhall .ru › vankomicin
Ванкомицин (Vancomycin) Фармакологическое действие: Ванкомицин относится к группе трициклических гликопептидных антибиотиков, оказывает бактерицидное действие, которое обусловлено способностью лекарственного препарата оказывать блокирующее воздействие на процесс синтеза клеточной мембраны и нарушать синтез РНК вредоносных микроорганизмов .
Ванкомицин относится к группе противомикробных препаратов, оказывающих бактерицидное . . .
Ванкомицин относится к антибактериальным препаратам группы гликопептидов (высокомолекулярных углеводосодержащих антибиотиков) . Оказывает бактерицидное действие посредством нарушения синтеза клеточной стенки, снижения проницаемости цитоплазматических мембран и подавления синтеза рибонуклеиновых кислот клеток бактерий .
Лекарственный мониторинг Ванкомицина . Лекарственный мониторинг Ванкомицина - определение концентрации ванкомицина в крови . Vancomycin Ванкомицин относится к группе антибиотиков гликопептидов .
Описание препарата Ванкомицин Антибиотик используется при патологиях, вызванных преимущественно стафилококками, стрептококками, энтерококками, клостридиями, листериями и коринебактериями . Механизм действия Ванкомицина связан с его способностью менять проницаемость клеточной мембраны микробов, а также блокировать синтез РНК и белка .
Метронидазол В Ветеринарии
Помогает Ли Валосердин При Высоком Пульсе
Диабетон Показания К Применению
Клиндамицин 2 Крем Цена
Сколько Лежать Свеча Гексикон
Лютеин Форте Производитель
Верапамил Аналоги И Заменители В Ампулах
Нурофен Таблетки Сколько Дать Ребенку
Аналог Таблеток Нифекард
Мазь Розамет Цена Спб
Лазолван Плюс Цена
К Раствору Нитрата Кальция Массой 80 Г
Таблетки Ребамипид Инструкция По Применению Цена
Умифеновир При Коронавирусной Инфекции
Клексан Когда Начинать Колоть
Вольтарен Отзывы
Кето Плюс 2 Шампунь
Пантогам Капсулы Цена
Лекарство От Давления Повышенного Перинева
После Лечения Немозолом Как Выходят Глисты
Что Лечит Препарат Гептрал
Метформин Цена В Алматы
Эгилок При Повышенном Пульсе
Гинкго Запрещен В России
Диоксидин Для Обработки Ран
Гиперикум Фото
Иноферт Производитель
Хитозан При Онкологии Отзывы
Гриппферон Спрей Цена 500
Содержит Трипсин
Отипакс Ушные Капли Беременным
СПб Аптеки Бромгексин Берлин Хеми
Т Таваник 500 Инструкция
Нурофен Экспресс Леди Цена
Сотри Лишнее Dop2 Уровень 109
Стрезам При Панических Атаках
Флемоксин Солютаб Детский Суспензия
Народное Средство От Гайморита С Бициллином
Специфический Иммуноглобулин G
Нурофен Сироп Можно Беременным
Ко Перинева 1.25 4 Отзывы Врачей
Антагонисты Кальция Противопоказаны При
Как Правильно Применять Изофру
Парацетамол Не Сбивает Температуру У Ребенка
Аптека Вита Долобене
Максиколд От Температуры
Гиалуформ Лифт Бустер
Сертамикол Крем Инструкция По Применению Отзывы
Цефазолин Уколы Видео
Маалокс При Рвоте
Анализ На Иммуноглобулин Igm Igg
Таблетки Эльжина Побочки
Супракс Наличие
Вильпрафен При Уреаплазме У Женщин
Изониазид Антивитамин Для Витамина
Отофа Аналоги Для Детей
Кальцемин Адванс Вологда Цена
Викасол Таблетки При Геморрое Отзывы
Задержка После Джес Плюс
Очищающая Маска Из Полисорба
Диротон 5 Мг Цена 56 Таблеток
Контрактубекс Чешется Шрам
Омнитус 50 Мг
Спиолто Респимат Гормональный Или Нет
Де Нол И Омез Одно И Тоже
Левофлоксацин 500 Отзовик
Количественное Определение Кальция
Курск Цена Дайвонекс
Цефтриаксон Инструкция Уколы Внутримышечно При Пневмонии
Месяц После Приема Постинора
Обладает Ли Индинол Форто Противовоспалительным Действием
Кардосал 10 Отзывы Форум
Депакин При Шизофрении
Отравление Ноотропами
Ярина Таблетки Отзывы Женщин После 40
Вальсакор 160 Цена 90 Шт
Ксамиол Крем
Лекарство Лоцерил Цена
Целебрекс После Перелома Ноги Отзывы
Циннаризин 25мг Отзывы
Перинева Бисопролола
Пентовит Применение Отзывы
Сколько Стоит Хофитол В Аптеках
Грандаксин Красноярск
Лактофильтрум Цена В Туле В Аптеке
Тамифлю И Галавит
Моксонидин Амлодипин Вместе
Синупрет Цена В Омске Фармакопейка
Мовалис Таблетки 15 Мг Цена 10 Шт
Сколько Стоит Бисакодил В Таблетках
Мирамистин После Проститутки
Элеутерококка Экстракт Показания К Применению Отзывы
Цефотаксим Уколы С Чем Разбавлять Лучше
Крем С Глицерином Для Лица Отзывы
Гриппферон Цена Тольятти Спрей
Сколько Мезима Дать Ребенку 3 Года
Экзон Рф Самостоятельная Подготовка
Окувайт Форте Таблетки 30 Шт
Метотрексат Цена В Краснодаре
Фарингосепт Цена Апрель
Ванкомицин Относится




























-turcija-vankomicin-vista-500-mg-liofilizat-dlja-rastvora-dlja-infuzij-flakon-20-ml-%E2%84%961-20.jpg">









-borispol-)-vankomicin-rastvor-dlja-in-ekcij-500-mg-20.jpg">



borispil-)-vankomicin-farmeks-500-mg-liofilizat-dlja-rastvora-dlja-infuzij-%E2%84%961-20.jpg">

-turcija-vankomicin-vista-liofilizat-dlja-rastvora-dlja-infuzij-po-1000-mg-v-flakone-20-ml-1-sht-20.jpg">

/81/1.png)














